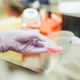
Captura de pantalla 2021 05 14 a la(s) 18.28.06 1

-
 This is traced back to when copper was found and substituted stone as a tool-making material. Smelting was used to obtain it. This research culminated in the creation of more powerful arms and tools. Early cultures were able to share technology and wisdom more easily thanks to the trading of these resources. From transportation to electricity, from housing to healthcare, from food to electronics, metals are now found in nearly every part of modern society.
This is traced back to when copper was found and substituted stone as a tool-making material. Smelting was used to obtain it. This research culminated in the creation of more powerful arms and tools. Early cultures were able to share technology and wisdom more easily thanks to the trading of these resources. From transportation to electricity, from housing to healthcare, from food to electronics, metals are now found in nearly every part of modern society. -
 The first human civilizations were already having a strong knowledge of medicine. In the past, primitive medicine linked illness to spiritual or mythical causes. Plants, earth, animal fats, and other natural remedies were used to treat diseases. There have clearly been advancements, and we have made significant progress in combating many of the main causes of death and illness. Life expectancy has risen significantly, child and maternal mortality rates have fallen, and so on.
The first human civilizations were already having a strong knowledge of medicine. In the past, primitive medicine linked illness to spiritual or mythical causes. Plants, earth, animal fats, and other natural remedies were used to treat diseases. There have clearly been advancements, and we have made significant progress in combating many of the main causes of death and illness. Life expectancy has risen significantly, child and maternal mortality rates have fallen, and so on. -
 Many traditional building materials began to be noticed around 3000 B.C. They assisted man in the development of agricultural tools, hunting and war equipment, and eating utensils, as well as other elements and tools that became key in their evolution. Materials are now becoming increasingly important in national growth, and most developed countries are investing heavily in their development as a result of their strategic significance in global economic interaction.
Many traditional building materials began to be noticed around 3000 B.C. They assisted man in the development of agricultural tools, hunting and war equipment, and eating utensils, as well as other elements and tools that became key in their evolution. Materials are now becoming increasingly important in national growth, and most developed countries are investing heavily in their development as a result of their strategic significance in global economic interaction. -
 The Ogdoad is made up of four pairs of gods, who together personify the primordial liquid chaos that existed before the World was made. This Egyptians formulate the theory of the Ogdoad, or "the primordial forces" (forces of the Universe that cannot be explained in terms of other), of which everything was formed. These were the elements of Chaos, that existed even before the creation of the Sun and mainly, the idea of force is required to comprehend why bodies move.
The Ogdoad is made up of four pairs of gods, who together personify the primordial liquid chaos that existed before the World was made. This Egyptians formulate the theory of the Ogdoad, or "the primordial forces" (forces of the Universe that cannot be explained in terms of other), of which everything was formed. These were the elements of Chaos, that existed even before the creation of the Sun and mainly, the idea of force is required to comprehend why bodies move. -
 The first mention of electrical phenomena is found in ancient Egyptian texts around 2,750 BC (about 4,750 years ago). It is a positive development of the community. Energy is one of the most important resources in today's society and without it, the quality of living would drop, because it would be impossible to fit in because we already have a new way of life.
The first mention of electrical phenomena is found in ancient Egyptian texts around 2,750 BC (about 4,750 years ago). It is a positive development of the community. Energy is one of the most important resources in today's society and without it, the quality of living would drop, because it would be impossible to fit in because we already have a new way of life. -
 All objects, according to Empedocles, are made up of four primary elements: earth, air, fire, and water, which are acted upon by two conflicting and powerful powers, which end up merging or dividing them in endlessly varying ways. Despite flaws in his theory, it was a significant step forward in scientific thinking, because he was one of the first to propose that certain objects that seemed to be pure materials, are likely made up of a mixture of various "elements."
All objects, according to Empedocles, are made up of four primary elements: earth, air, fire, and water, which are acted upon by two conflicting and powerful powers, which end up merging or dividing them in endlessly varying ways. Despite flaws in his theory, it was a significant step forward in scientific thinking, because he was one of the first to propose that certain objects that seemed to be pure materials, are likely made up of a mixture of various "elements." -
 Democritus was a Greek philosopher who adopted the name "atom" for the first time (atomos: meaning indivisible). He believed that if you split a piece of matter and begin to divide it, you would inevitably reach a point where you can't longer divide it. Democritus referred to this fundamental or essential unit as an atom. These are important to study since matter is made up of them, which is then divided into protons, electrons, and neutrons, which are further divided into quarks.
Democritus was a Greek philosopher who adopted the name "atom" for the first time (atomos: meaning indivisible). He believed that if you split a piece of matter and begin to divide it, you would inevitably reach a point where you can't longer divide it. Democritus referred to this fundamental or essential unit as an atom. These are important to study since matter is made up of them, which is then divided into protons, electrons, and neutrons, which are further divided into quarks. -
 Alchemy's aim is to learn about the transmutation of matter, whether for theological or esoteric reasons.
Alchemy's aim is to learn about the transmutation of matter, whether for theological or esoteric reasons.
Most alchemists consider Hermes Trismegistus, the father of the science, and Pharaoh Cheops, who authored the first treatise on alchemy, the oldest alchemist. All this began in Alexandria and rapidly spread, but by the 16th century, it got almost extinct, so alchemists were suspected of forging pacts with witches, and the Catholic Church's Inquisition accused and burned them alive. -
 Humans, as well as animals and plants, would become extinct without access to oxygen.
Humans, as well as animals and plants, would become extinct without access to oxygen.
Antoine Lavoisier clarifies the nature of the elements after Joseph Priestley finds oxygen. In tests, Priestley produces oxygen and explains its function in combustion and respiration. -
 Eight gases, including oxygen, were isolated and characterized by this Englishman. Priestley also made significant contributions to the study of photosynthesis and respiration.
Eight gases, including oxygen, were isolated and characterized by this Englishman. Priestley also made significant contributions to the study of photosynthesis and respiration.
Priestley began his studies on gas properties in the 1770s while staying next to a brewery, which provided him with an abundant supply of carbon dioxide. This is why Priestley's contribution to experimental chemistry is so important. -
 Calorimeter is an instrument for determining the heat potential of materials and measuring the heat produced during a mechanical, electrical, or chemical reaction. The first calorimeter was developed in 1789 by Antoine Lavoisier and mathematician Pierre Simon de La Place. However, it was the French chemist Marcellin Berthelot who built the first modern calorimeter in the 1860s.
Calorimeter is an instrument for determining the heat potential of materials and measuring the heat produced during a mechanical, electrical, or chemical reaction. The first calorimeter was developed in 1789 by Antoine Lavoisier and mathematician Pierre Simon de La Place. However, it was the French chemist Marcellin Berthelot who built the first modern calorimeter in the 1860s. -
 Berthollet was a French chemist who studied dyes and bleaches and was the first to use chlorine as a bleach. Now chlorine bleach is made by mixing water with sodium hypochlorite, a chlorine-based compound. This commercially available substance is often used as a laundry bleaching or disinfectant agent, as well as a general disinfectant.
Berthollet was a French chemist who studied dyes and bleaches and was the first to use chlorine as a bleach. Now chlorine bleach is made by mixing water with sodium hypochlorite, a chlorine-based compound. This commercially available substance is often used as a laundry bleaching or disinfectant agent, as well as a general disinfectant. -
 When researching the function of batteries, William Nicholson made an unintentional discovery. Michael Faraday, invented and published the laws of electrolysis, as well as coining the terminology, and Humphry Davy, an English chemist, used electrolysis to decompose several molten salts, discovering sodium and potassium. Through this process, we break down materials into their constituent parts, purify metals, and coat certain metals with another metal to beautify or protect them from corrosion.
When researching the function of batteries, William Nicholson made an unintentional discovery. Michael Faraday, invented and published the laws of electrolysis, as well as coining the terminology, and Humphry Davy, an English chemist, used electrolysis to decompose several molten salts, discovering sodium and potassium. Through this process, we break down materials into their constituent parts, purify metals, and coat certain metals with another metal to beautify or protect them from corrosion. -
 Dalton's law, which relates the partial pressures of the components of a gas mixture, was introduced by John Dalton in 1803.
Dalton's law, which relates the partial pressures of the components of a gas mixture, was introduced by John Dalton in 1803.
It is now very useful when we want to determine the relationship between the partial pressures and the total pressure of a gas mixture. -
 Justus von Liebig was a brilliant chemist. He was mostly interested in organic chemistry, where he pioneered new methods of study. On the discovery of benzoic acid and uric acid, as well as the fermentation methods, he collaborated with German chemist Friedrich Wöhler. He stated that plants eat inorganic matter from the soil and the environment and convert it to organic matter, which led him to successfully test fertilizer use.
Justus von Liebig was a brilliant chemist. He was mostly interested in organic chemistry, where he pioneered new methods of study. On the discovery of benzoic acid and uric acid, as well as the fermentation methods, he collaborated with German chemist Friedrich Wöhler. He stated that plants eat inorganic matter from the soil and the environment and convert it to organic matter, which led him to successfully test fertilizer use. -
 The most important theory in the history of science, according to some, is atomic theory. We can use it to describe the rules of chemical combination and all possible outcomes. According to John Dalton's principle, matter is made up of very small particles called atoms that are indivisible and unbreakable. Atoms of the same element are identical, have the same mass, and have the same properties. Atoms of different elements have different masses.
The most important theory in the history of science, according to some, is atomic theory. We can use it to describe the rules of chemical combination and all possible outcomes. According to John Dalton's principle, matter is made up of very small particles called atoms that are indivisible and unbreakable. Atoms of the same element are identical, have the same mass, and have the same properties. Atoms of different elements have different masses. -
 Ordinary gases, according to Avogadro, are made up of molecules containing two or three atoms rather than single atoms (which was the origin of the different atomic weights recorded). The oxygen molecule split into two atoms to form water, according to Avogadro. Equal volumes of different gases, under the same pressure and temperature conditions, contain the same number of molecules. The Avogadro theorem is now the basis for the method of atomic weights and formulation.
Ordinary gases, according to Avogadro, are made up of molecules containing two or three atoms rather than single atoms (which was the origin of the different atomic weights recorded). The oxygen molecule split into two atoms to form water, according to Avogadro. Equal volumes of different gases, under the same pressure and temperature conditions, contain the same number of molecules. The Avogadro theorem is now the basis for the method of atomic weights and formulation. -
 Frederick Gowland Hopkins was conducting his work on animal nutrition, focused primarily on energy requirements. Hopkins disproved a theory, by showing that tiny animals including mice couldn't live purely on protein, vegetables, fats, and some inorganic materials. Mice and other animals needed "accessory factors" — compounds that would become known as vitamins, in order to develop and be healthy. In 1929, he was awarded the Nobel Prize in Medicine for his work on metabolism and diet.
Frederick Gowland Hopkins was conducting his work on animal nutrition, focused primarily on energy requirements. Hopkins disproved a theory, by showing that tiny animals including mice couldn't live purely on protein, vegetables, fats, and some inorganic materials. Mice and other animals needed "accessory factors" — compounds that would become known as vitamins, in order to develop and be healthy. In 1929, he was awarded the Nobel Prize in Medicine for his work on metabolism and diet. -
 Friedrich Woehler mistakenly synthesizes urea from inorganic materials, demonstrating that compounds created by living organisms can be duplicated using inert materials. The significance of urea, comes from the fact that it was formerly believed that the substances that made life possible could only be "manufactured" by living beings.
Friedrich Woehler mistakenly synthesizes urea from inorganic materials, demonstrating that compounds created by living organisms can be duplicated using inert materials. The significance of urea, comes from the fact that it was formerly believed that the substances that made life possible could only be "manufactured" by living beings. -
 The bunsen burner is a laboratory device that is used to heat samples and chemicals. While the laboratory burners were already in use when Bunsen came along. Michael Faraday, an English scientist, was credited with developing one of the first prototypes. Bunsen's design changes were thought to be the most effective. Bunsen helped pioneer the use of spectroscopy in chemical analysis, in addition to improving the common lab tool.
The bunsen burner is a laboratory device that is used to heat samples and chemicals. While the laboratory burners were already in use when Bunsen came along. Michael Faraday, an English scientist, was credited with developing one of the first prototypes. Bunsen's design changes were thought to be the most effective. Bunsen helped pioneer the use of spectroscopy in chemical analysis, in addition to improving the common lab tool. -
 The molecular composition of a chemical substance shows the connections between the various atoms or ions that make up a molecule, or atomic aggregate. Friedrich Kekulé discovers the chemical structure of benzene, elevating molecular structure research into the spotlight. In two papers written in 1857 and 1858, he outlined it, and in his famous work "Manual of organic chemistry," he developed it in great detail.
The molecular composition of a chemical substance shows the connections between the various atoms or ions that make up a molecule, or atomic aggregate. Friedrich Kekulé discovers the chemical structure of benzene, elevating molecular structure research into the spotlight. In two papers written in 1857 and 1858, he outlined it, and in his famous work "Manual of organic chemistry," he developed it in great detail. -
 The periodic table was formulated by Dmitry Mendeleyev to make it easier to classify known elements. He anticipated some elements that had yet to be identified, as well as sensed an order between them. He spent more than thirty years gathering data and forming the concept.
The periodic table was formulated by Dmitry Mendeleyev to make it easier to classify known elements. He anticipated some elements that had yet to be identified, as well as sensed an order between them. He spent more than thirty years gathering data and forming the concept.
It's now perfect for looking at associations between element properties or predicting properties of elements that haven't been synthesized or discovered yet. -
 Pasteurization is a thermal procedure that is performed on liquids in order to reduce the presence of contaminants. The aim is to keep the food healthier to eat while also extending their shelf life. Despite the fact that it is a process that many people have studied in the past, Louis Pasteur is the man who has been given the distinction of discovering it, since he linked heat to bacteria death while on vacation in 1864.
Pasteurization is a thermal procedure that is performed on liquids in order to reduce the presence of contaminants. The aim is to keep the food healthier to eat while also extending their shelf life. Despite the fact that it is a process that many people have studied in the past, Louis Pasteur is the man who has been given the distinction of discovering it, since he linked heat to bacteria death while on vacation in 1864. -
 In the absence of oxygen from glucose, the biological purpose of alcoholic fermentation is to supply anaerobic energy to unicellular microorganisms, so this is needed for the production of wine, beer, whisky, rum, and vodka, and Harden was a key figure in the study of the process. Harden researched the fermentation of sugar by yeast as a chemist at the British Institute of Preventative Medicine, later called the Lister Institute.
In the absence of oxygen from glucose, the biological purpose of alcoholic fermentation is to supply anaerobic energy to unicellular microorganisms, so this is needed for the production of wine, beer, whisky, rum, and vodka, and Harden was a key figure in the study of the process. Harden researched the fermentation of sugar by yeast as a chemist at the British Institute of Preventative Medicine, later called the Lister Institute. -
 Adolf Von Baeyer made his first chemical discovery at the age of 12. A new double copper salt. In 1865, he started to produce indigo, the blue dye used to colour most denim, and several years later, he successfully synthesized the dye. For his "research on organic dyes and hydroaromatic compounds" he received the Nobel Prize in Chemistry in 1905.
Adolf Von Baeyer made his first chemical discovery at the age of 12. A new double copper salt. In 1865, he started to produce indigo, the blue dye used to colour most denim, and several years later, he successfully synthesized the dye. For his "research on organic dyes and hydroaromatic compounds" he received the Nobel Prize in Chemistry in 1905.
Thanks to that, textiles are hypoallergenic, antibacterial, and skin-soothing, making them suitable for people with sensitive skin and allergies. -
 It was invented by Alfred Nobel on May 6, 1867, and despite the fact that the inventor was a pacifist, it has played an important role in Contemporary history. Dynamite was invented, and it revolutionized mining and public works around the world, bringing fame and, most importantly, enormous fortune to its creator. In uses such as demolitions and mining, as well as as an explosive filler in mortar shells and military demolition charges, dynamite rapidly replaced nitroglycerin.
It was invented by Alfred Nobel on May 6, 1867, and despite the fact that the inventor was a pacifist, it has played an important role in Contemporary history. Dynamite was invented, and it revolutionized mining and public works around the world, bringing fame and, most importantly, enormous fortune to its creator. In uses such as demolitions and mining, as well as as an explosive filler in mortar shells and military demolition charges, dynamite rapidly replaced nitroglycerin. -
 Despite the fact that thousands of elephants were slaughtered each year, the world faced an unusual situation in the 1860s: ivory was in short supply to satisfy global demand for billiard balls and piano keys. A tusk was only worth three balls. Hyatt, an American inventor, created a suitable material by combining cellulose nitrate, camphor, and alcohol. He came up with the term "Celluloid" for the item, which was the first thermoplastic, and established a corporation to produce and sell it.
Despite the fact that thousands of elephants were slaughtered each year, the world faced an unusual situation in the 1860s: ivory was in short supply to satisfy global demand for billiard balls and piano keys. A tusk was only worth three balls. Hyatt, an American inventor, created a suitable material by combining cellulose nitrate, camphor, and alcohol. He came up with the term "Celluloid" for the item, which was the first thermoplastic, and established a corporation to produce and sell it. -
 The periodic table in the elements organizes the elements in nature by atomic number and chemical properties, and it was created by a number of scientists, but Mendeleev is best known for publishing the first widely accepted version in 1869. He developed his time table and used his method to estimate the properties of yet-to-be found elements while working at St. Petersburg University.
The periodic table in the elements organizes the elements in nature by atomic number and chemical properties, and it was created by a number of scientists, but Mendeleev is best known for publishing the first widely accepted version in 1869. He developed his time table and used his method to estimate the properties of yet-to-be found elements while working at St. Petersburg University. -
 The work of J. Willard Gibbs on thermodynamic applications was crucial in transforming physical chemistry into a systematic deductive discipline. Gibbs experimented on the theory of thermodynamics from 1876 to 1878, extending them to the diverse mechanisms involved in chemical reactions. He specified chemical potential, or the likelihood of a chemical reaction occurring. The practical importance of this, lies fundamentally in the diversity of physical phenomena it describes.
The work of J. Willard Gibbs on thermodynamic applications was crucial in transforming physical chemistry into a systematic deductive discipline. Gibbs experimented on the theory of thermodynamics from 1876 to 1878, extending them to the diverse mechanisms involved in chemical reactions. He specified chemical potential, or the likelihood of a chemical reaction occurring. The practical importance of this, lies fundamentally in the diversity of physical phenomena it describes. -
 Remsen, a former president of Johns Hopkins University, is credited with the invention of saccharin, a popular artificial sweetener. Saccharin is still commonly used in the United States, and can be used in anything from diet soft drinks to toothpaste. Sweeteners, according to food manufacturers, tend to inhibit tooth decay, regulate blood sugar levels, and decrease calorie consumption.
Remsen, a former president of Johns Hopkins University, is credited with the invention of saccharin, a popular artificial sweetener. Saccharin is still commonly used in the United States, and can be used in anything from diet soft drinks to toothpaste. Sweeteners, according to food manufacturers, tend to inhibit tooth decay, regulate blood sugar levels, and decrease calorie consumption. -
 In 1883, almost 50 years after the photovoltaic effect was discovered, American inventor Charles Fritz invented the first practical selenium solar cell. Although modern solar panel cells use silicon, this solar cell was a significant precursor to the technology used today.
In 1883, almost 50 years after the photovoltaic effect was discovered, American inventor Charles Fritz invented the first practical selenium solar cell. Although modern solar panel cells use silicon, this solar cell was a significant precursor to the technology used today.
The electricity generated by solar panels helps to offset greenhouse gas emissions and climate change; it also reduces reliance on nonrenewable energy sources that harm the environment; and it also promotes rural growth. -
 Vaccines help to strengthen the immune system and protect against dangerous and life-threatening infections. Pasteur’s groundbreaking inventions saved lives all over the world by preventing illnesses. The discovery of French scientist on germ theory contributed to anthrax and rabies vaccines in the nineteenth century. In 1885, Pasteur gained recognition after vaccinating Joseph Meister, a 9-year-old boy who had been attacked by a rabid dog.
Vaccines help to strengthen the immune system and protect against dangerous and life-threatening infections. Pasteur’s groundbreaking inventions saved lives all over the world by preventing illnesses. The discovery of French scientist on germ theory contributed to anthrax and rabies vaccines in the nineteenth century. In 1885, Pasteur gained recognition after vaccinating Joseph Meister, a 9-year-old boy who had been attacked by a rabid dog. -
 The world's first commercial movie screening takes place at the Grand Cafe in Paris. It's a short film directed by Louis Le Prince, a French inventor. It's technically a movie, even though it's just 2.11 seconds long.
The world's first commercial movie screening takes place at the Grand Cafe in Paris. It's a short film directed by Louis Le Prince, a French inventor. It's technically a movie, even though it's just 2.11 seconds long.
Many films provide viewers with diverse viewpoints, allowing us to identify with the characters, immerse ourselves in their worlds, and see their transformation over time. By rethinking crazy thoughts and changing our behavior, these stories help us focus on cognitive approach. -
 X-rays are particularly useful for identifying skeletal disorders, but they can also be used to identify soft tissue diseases like pneumonia, lung cancer, pulmonary edema, and abscesses. They were discovered accidentally by Wilhem Roetgen. He was experimenting with cathode ray radiation at the time of his discovery. It was then that he realized that rays can be fixed on opaque black paper as it is placed around a cathode ray tube. This results in a shape that gleams brightly.
X-rays are particularly useful for identifying skeletal disorders, but they can also be used to identify soft tissue diseases like pneumonia, lung cancer, pulmonary edema, and abscesses. They were discovered accidentally by Wilhem Roetgen. He was experimenting with cathode ray radiation at the time of his discovery. It was then that he realized that rays can be fixed on opaque black paper as it is placed around a cathode ray tube. This results in a shape that gleams brightly. -
 Henri Becquerel started using naturally fluorescent minerals to research the properties of x-rays in 1896. He then conducted tests, which failed, but Becquerel persevered and discovered that the mineral uranium did emit radiation without the assistance of the sun. Today, the advantages include nuclear technology, sterilization, and surgical treatments that save millions of lives.
Henri Becquerel started using naturally fluorescent minerals to research the properties of x-rays in 1896. He then conducted tests, which failed, but Becquerel persevered and discovered that the mineral uranium did emit radiation without the assistance of the sun. Today, the advantages include nuclear technology, sterilization, and surgical treatments that save millions of lives. -
 Before the discovery of the atomic nucleus in 1904, J. J. Thomson, who found the neutron in 1897, suggested the plum pudding model of the atom in order to incorporate the electron in the atomic model. The atom, according to Thomson's model, is made up of electrons (which Thomson used to refer to as "corpuscles". The aim of these models is to simplify the analysis of this material level by abstracting the atom's logic and moving it to a scheme.
Before the discovery of the atomic nucleus in 1904, J. J. Thomson, who found the neutron in 1897, suggested the plum pudding model of the atom in order to incorporate the electron in the atomic model. The atom, according to Thomson's model, is made up of electrons (which Thomson used to refer to as "corpuscles". The aim of these models is to simplify the analysis of this material level by abstracting the atom's logic and moving it to a scheme. -
 Using a cathode ray tube, Joseph John Thomson discovered the electron in 1897. Wilhelm Wien demonstrated in 1898 that magnetic fields could redirect channel rays (a stream of positive ions), and that the deflection was proportional to their mass-charge ratio. This discovery will serve as the foundation for establishing the chemical analysis method known as mass spectrometry, in addition to aiding in the understanding of the composition of atom nuclei.
Using a cathode ray tube, Joseph John Thomson discovered the electron in 1897. Wilhelm Wien demonstrated in 1898 that magnetic fields could redirect channel rays (a stream of positive ions), and that the deflection was proportional to their mass-charge ratio. This discovery will serve as the foundation for establishing the chemical analysis method known as mass spectrometry, in addition to aiding in the understanding of the composition of atom nuclei. -
 In 1907, Belgian-American chemist Leo Baekeland made history by creating Bakelite, the first fully synthetic mass-produced plastic, by combining carbolic acid and formaldehyde. Plastic became popular for saving costs and allowing the use less natural resources.
In 1907, Belgian-American chemist Leo Baekeland made history by creating Bakelite, the first fully synthetic mass-produced plastic, by combining carbolic acid and formaldehyde. Plastic became popular for saving costs and allowing the use less natural resources.
Today, it is used in food processing, household equipment, car parts, building, artificial turf, suitcase shells, medical products, plastic bags, etc, but it is one of the most significant threats to biodiversity. -
 Nitrogen is essential for all living things' biochemistry, but plants and animals can't get it from the air. Yet when chemists Fritz Haber and Carl Bosch combined atmospheric nitrogen and hydrogen to form ammonia in 1910, everything changed. This got used as seed fertilizer, reaching us across the food chain.
Nitrogen is essential for all living things' biochemistry, but plants and animals can't get it from the air. Yet when chemists Fritz Haber and Carl Bosch combined atmospheric nitrogen and hydrogen to form ammonia in 1910, everything changed. This got used as seed fertilizer, reaching us across the food chain.
The Haber-Bosch process is responsible for around 80% of the nitrogen in our bodies today, making it the single most significant element in the population explosion of the last 100 years. -
 Alexander Fleming is credited with discovering penicillin, when he noticed how a mould suppressed the growth of surrounding bacteria. Despite his best intentions, he was unable to obtain any available penicillin. Fleming gave up, and the tale of penicillin was put on hold for ten years. Later, Howard Florey and his team of chemists worked until 1939 to get to know how to purify penicillin in large enough amounts to be useful. Penicillins are still used in medicine on a daily basis.
Alexander Fleming is credited with discovering penicillin, when he noticed how a mould suppressed the growth of surrounding bacteria. Despite his best intentions, he was unable to obtain any available penicillin. Fleming gave up, and the tale of penicillin was put on hold for ten years. Later, Howard Florey and his team of chemists worked until 1939 to get to know how to purify penicillin in large enough amounts to be useful. Penicillins are still used in medicine on a daily basis. -
 Wallace Carothers and his team at the DuPont chemical company developed the first strong and flexible synthetic polymer fiber strand in the early 1930s. In 1935, DuPont patented the thread as "nylon," and Carothers was elected to the National Academy of Sciences as the first organic chemist.
Wallace Carothers and his team at the DuPont chemical company developed the first strong and flexible synthetic polymer fiber strand in the early 1930s. In 1935, DuPont patented the thread as "nylon," and Carothers was elected to the National Academy of Sciences as the first organic chemist.
Nylon is ideal because it has excellent abrasion and wear resistance, good tensile and compressive strength, a low coefficient of friction, is a lightweight material, and it is simple to machine. -
 Linus Pauling, an American chemist, made significant contributions to the fields of organic, inorganic, analysis, and biochemistry, as well as genetic disorders, hematology, immunology, brain functions and neuroscience, nutritional therapy, epidemiology, and biomedicine. He is considered as the founder of molecular biology as a result of all of this.
Linus Pauling, an American chemist, made significant contributions to the fields of organic, inorganic, analysis, and biochemistry, as well as genetic disorders, hematology, immunology, brain functions and neuroscience, nutritional therapy, epidemiology, and biomedicine. He is considered as the founder of molecular biology as a result of all of this. -
 Analgesics are used to relieve common postoperative pain, extreme pain, and a variety of other disorders.These help bettering one's quality of life because pain can affect one's mood and ability to think. In the nineteenth century, a scientific approach to pain management became possible. The discovery of two potent naturally occurring analgesic pentapeptides in pig brain extracts by neuroscientists John W. Hughes and Hans W. Kosterlitz was the first true breakthrough.
Analgesics are used to relieve common postoperative pain, extreme pain, and a variety of other disorders.These help bettering one's quality of life because pain can affect one's mood and ability to think. In the nineteenth century, a scientific approach to pain management became possible. The discovery of two potent naturally occurring analgesic pentapeptides in pig brain extracts by neuroscientists John W. Hughes and Hans W. Kosterlitz was the first true breakthrough. -
 Luis Ernesto Miramontes, an important Mexican chemist, was responsible for a number of chemical patents, but his main contribution to the field of chemistry was in the pharmacy field, when he invented the first oral contraceptive. This discovery not only made him popular around the globe, but it also influenced the growth of family planning around the world.
Luis Ernesto Miramontes, an important Mexican chemist, was responsible for a number of chemical patents, but his main contribution to the field of chemistry was in the pharmacy field, when he invented the first oral contraceptive. This discovery not only made him popular around the globe, but it also influenced the growth of family planning around the world. -
 Insulin’s purpose is to facilitate the absorption of glucose from the blood into the cells, and Frederick Sanger, a British biochemist, found new methods to order amino acids, which led to the establishment of the insulin structure. Sanger received the Nobel Prize in Chemistry in 1948 for his work on insulin, among several other honors and distinctions.
Insulin’s purpose is to facilitate the absorption of glucose from the blood into the cells, and Frederick Sanger, a British biochemist, found new methods to order amino acids, which led to the establishment of the insulin structure. Sanger received the Nobel Prize in Chemistry in 1948 for his work on insulin, among several other honors and distinctions. -
 Taxol is one of the world's most effective cancer treatments. This medication acts by blocking cells from dividing, resulting in cell death. Monroe Wall and Mansukh Wani discovered it in the 1960s. These two medicinal chemists, found a cell-toxic agent inside samples form trees and plants. It was given the name paclitaxel, and it was subjected to extensive laboratory testing for the next few decades before being used in patients in 1992.
Taxol is one of the world's most effective cancer treatments. This medication acts by blocking cells from dividing, resulting in cell death. Monroe Wall and Mansukh Wani discovered it in the 1960s. These two medicinal chemists, found a cell-toxic agent inside samples form trees and plants. It was given the name paclitaxel, and it was subjected to extensive laboratory testing for the next few decades before being used in patients in 1992. -
 Smartphones and social media networks have transformed our lives, but only thanks to LCD screens, which are bright, tiny, and fit in a pocket. This was made possible thanks to George Gray, who researched the phenomenon. His discovery led to the creation of a new molecule that behaved at a lower temperature, the 5CB molecule, which has since been used in most LCD displays.
Smartphones and social media networks have transformed our lives, but only thanks to LCD screens, which are bright, tiny, and fit in a pocket. This was made possible thanks to George Gray, who researched the phenomenon. His discovery led to the creation of a new molecule that behaved at a lower temperature, the 5CB molecule, which has since been used in most LCD displays. -
 Mario Molina is a the Mexican scientist who rose to international prominence as a result of his findings and experiments in atmospheric chemistry, as well as his prediction of ozone layer thinning as a result of the release of some industrial gases. Atmospheric chemistry aims to discover the root causes of these issues and, by having a scientific knowledge of them, so this allows us to make the research of potential solutions and the evaluation of the results of policy changes.
Mario Molina is a the Mexican scientist who rose to international prominence as a result of his findings and experiments in atmospheric chemistry, as well as his prediction of ozone layer thinning as a result of the release of some industrial gases. Atmospheric chemistry aims to discover the root causes of these issues and, by having a scientific knowledge of them, so this allows us to make the research of potential solutions and the evaluation of the results of policy changes. -
 In 2010, a group of researchers published the first fully complete genome of an ancient Homo sapiens, setting off a decade of groundbreaking studies into our ancestors' DNA. Since then, over 3,000 ancient genomes have been sequenced. This helps us create a strong sense of who we are through understanding our cultural history and where we came from. The way we connect to our family history contributes to the creation of our distinct and authentic basic identity.
In 2010, a group of researchers published the first fully complete genome of an ancient Homo sapiens, setting off a decade of groundbreaking studies into our ancestors' DNA. Since then, over 3,000 ancient genomes have been sequenced. This helps us create a strong sense of who we are through understanding our cultural history and where we came from. The way we connect to our family history contributes to the creation of our distinct and authentic basic identity. -
 Australopithecus sediba, a distant ancestor, was discovered in 2010 by an explorer. He revealed five years later that the Cradle of Humankind cave complex in South Africa had fossils of a new species, whose form matches that of a contemporary human and is far more similar to relatives. Learning about our ancestors' lives, allows one to have a better sense of the difficulties they endured, as well as a deeper love and appreciation for their flaws and errors.
Australopithecus sediba, a distant ancestor, was discovered in 2010 by an explorer. He revealed five years later that the Cradle of Humankind cave complex in South Africa had fossils of a new species, whose form matches that of a contemporary human and is far more similar to relatives. Learning about our ancestors' lives, allows one to have a better sense of the difficulties they endured, as well as a deeper love and appreciation for their flaws and errors. -
 The first evidence of it, was found in 1987, but CRISPR-Cas9 was proposed as an effective gene editing technique in 2012, cutting DNA precisely in ways that scientists would easily customize. Within months, other teams verified that the procedure operated on human DNA. Since then, laboratories around the world have been searching for similar systems for altering Crispr-Cas9 and increasing its accuracy, as well as experimenting with its agricultural and medical applications.
The first evidence of it, was found in 1987, but CRISPR-Cas9 was proposed as an effective gene editing technique in 2012, cutting DNA precisely in ways that scientists would easily customize. Within months, other teams verified that the procedure operated on human DNA. Since then, laboratories around the world have been searching for similar systems for altering Crispr-Cas9 and increasing its accuracy, as well as experimenting with its agricultural and medical applications. -
 While there were hints of the waves' presence as early as the 1970s, no one was able to directly observe them until 2015. The observation, which was made public in 2016, ushered in a new way of "listening" to the universe. In 2017, the eruption was observed by telescopes all over the world. Scientists have gained incredible insight into the workings of gravity and the creation of elements like gold and silver thanks to this historical evidence.
While there were hints of the waves' presence as early as the 1970s, no one was able to directly observe them until 2015. The observation, which was made public in 2016, ushered in a new way of "listening" to the universe. In 2017, the eruption was observed by telescopes all over the world. Scientists have gained incredible insight into the workings of gravity and the creation of elements like gold and silver thanks to this historical evidence.
A list shows items. A timeline shows sequence.
Use Timetoast to make dates, milestones, and turning points easier to understand in a clear visual format. Timetoast is a timeline maker for work, school, research, and stories.